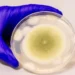
Researchers turn toxic fungus into potent anti-cancer compound

Blitz Bureau
NEW DELHI: For India, which reportedly holds crude reserves for 90 days, Saudi Arabia’s ability to reroute crude exports via the Red Sea offers a layer of supply continuity amid the Strait of Hormuz uncertainty, according to a report on June 23. While India sources 18–20 per cent of its crude from Saudi Arabia, the Petroline-Yanbu corridor ensures that a significant portion of these volumes could still reach Indian refiners even if the Hormuz route is disrupted.
“Although some logistical constraints and higher freight costs may persist, Saudi’s diversified export infrastructure, combined with India’s flexible sourcing strategy, reduces the likelihood of a sharp supply shortfall from this key partner,” said the report from Yes Securities. With Iran’s Parliament approving a potential closure of the Strait of Hormuz following US strikes on its nuclear sites, energy markets face rising disruption risk at the world’s most critical oil artery.
For India, which sources more than 35 per cent of crude and 42 per cent of LNG through the strait, the near-term threat lies in supply delays and freight escalation.
“However, India’s evolving import mix provides a strong cushion – Russian inflows (2.2 million barrels of oil per day, or mb/d, in June) now exceed combined Middle East supplies, and additions from the US, West Africa, and Latin America bypass Hormuz entirely,” the report contended.
India imports 5.5 mb/d of crude, with 2mb/d (over 35 per cent) from the Middle East transiting the Strait of Hormuz. Despite this logistical exposure, India’s crude sourcing strategy has materially evolved since 2022. “Russian imports now exceed those from all Middle Eastern suppliers combined. Additions from the US (0.44mb/d), Brazil, West Africa, and even Latin America offer alternate routes bypassing Hormuz via the Suez, Cape of Good Hope, and Pacific Ocean. India could ensure that supplies increase from Russia, the US and others,” the report mentioned. While fears of a total closure have resurfaced, historical precedent suggests that Iran is unlikely to fully blockade Hormuz.
Doing so would hurt its own crude exports (96 per cent routed via Kharg Island), alienate key partners like China (its largest buyer), and provoke coordinated military retaliation.